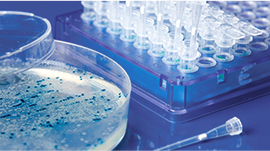
Lead Identification & Optimization

The PD-1 Pathway: A Revolutionary Target in Immunotherapy
Immunotherapy Introduction
Targeted therapies have emerged as powerful weapons in medicine's arsenal in the quest to combat complex diseases. While countless researchers dedicate their careers to understanding specific diseases and their pathologies, discovering an effective therapeutic target requires more than just understanding its biological function. The ideal target must demonstrate clear disease relevance, therapeutic potential, and a favorable safety profile.
Among the pantheon of therapeutic antibody targets—including EGFR, HER2, CD20, and TNF-α—PD-1 is a remarkable success story. With approximately 20 approved antibody drugs targeting PD-1 alone (reaching 31 when including its ligand PD-L1), this pathway has revolutionized cancer immunotherapy across global markets.
The PD-1 Checkpoint: Nature’s Double-Edged Sword
At its core, PD-1 serves as a critical immune checkpoint protein within our adaptive immune system. Think of immune checkpoints as the body's sophisticated control system, carefully balancing protection against threats while preventing autoimmune responses. PD-1 and its partner PD-L1 act as molecular "brakes" on the immune system, fine-tuning T-cell responses through their interaction. While PD-1 resides on T cells, PD-L1 is expressed by antigen-presenting cells (APCs), creating a regulatory dialogue that maintains immune homeostasis.
However, cancer cells have evolved to exploit this protective mechanism. By expressing PD-L1 on their surface, tumors can effectively "cloak" themselves from immune detection, suppressing the very T cells designed to eliminate them. This discovery has led to one of oncology's most significant breakthroughs in recent decades.

Graphical Abstract, unedited.
Parvez et al. Creative Commons License
Clinical Impact and Future Horizons
The 2014 approval of nivolumab and pembrolizumab for melanoma treatment marked just the beginning of PD-1's therapeutic potential. Today's landscape includes approximately 20 approved antibody drugs spanning various cancer types. These therapeutics work by disrupting the PD-1/PD-L1 interaction, essentially "releasing the brakes" on anti-tumor immune responses.
The field continues to evolve rapidly, with 2024 already witnessing four new approvals—including innovative bispecific antibodies that simultaneously target PD-1 and VEGF. The pipeline remains robust, with several candidates under review, including novel bispecific approaches combining PD-1 with TGF-β targeting.
Did this pique your interest on immune checkpoints? Check out our technical news article, which expands further on the immune checkpoint pathways and provides additional details on other essential targets not covered in this brief, like CTLA-4.
Find support and learn more about GenScript’s antibody drug discovery-related services:
TurboCHO Bispecific Antibody Design, Expression, and Purification
Off-the-shelf immune checkpoint proteins, antibodies, and cell lines
References
The Antibody Society. (2024, October 13). Antibody therapeutics product data - The Antibody Society. https://www.antibodysociety.org/antibody-therapeutics-product-data/.
Crescioli, S., Kaplon, H., Wang, L., Visweswaraiah, J., Kapoor, V., & Reichert, J. M. (2024). Antibodies to watch in 2025. mAbs, 17(1). https://doi.org/10.1080/19420862.2024.2443538
Li, G., Li, S., Jiang, Y., Chen, T., & An, Z. (2025). Unleashing the Power of immune Checkpoints: A new strategy for enhancing Treg cell depletion to boost antitumor immunity. International Immunopharmacology, 147, 113952. https://doi.org/10.1016/j.intimp.2024.113952
Parvez, A., Choudhary, F., Mudgal, P., Khan, R., Qureshi, K. A., Farooqi, H., & Aspatwar, A. (2023). PD-1 and PD-L1: architects of immune symphony and immunotherapy breakthroughs in cancer treatment. Frontiers in Immunology, 14. https://doi.org/10.3389/fimmu.2023.1296341
Zhang, P., Wang, Y., Miao, Q., & Chen, Y. (2023). The therapeutic potential of PD-1/PD-L1 pathway on immune-related diseases: Based on the innate and adaptive immune components. Biomedicine & Pharmacotherapy, 167, 115569. https://doi.org/10.1016/j.biopha.2023.115569